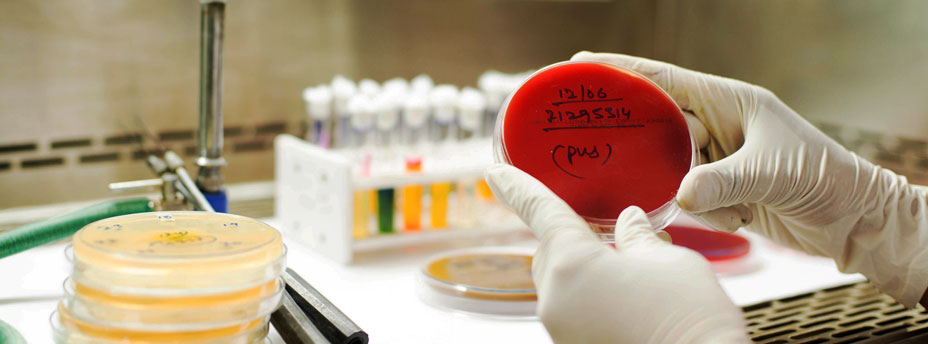

In Jharkhand, India, modern diagnostic centers provide comprehensive radiology and pathology diagnostic services at affordable prices. Iwan Bagus/IFC
When Phoolmani Devi, a housewife from a remote district in India’s Jharkhand state, developed painful swelling in the eighth month of her pregnancy, she needed specialty care to diagnose and treat her condition. But the services she so urgently required were not available at the local public hospital, and she couldn’t afford to pay up to $60 at a private facility. Her family doesn’t earn enough from farming to afford even basic family health care—so she was resigned to endure the pain and discomfort.
Devi’s situation is all too common in Jharkhand—a poor state with a vast tribal population where health and education indicators are much lower than the all-India average.
The state’s medical infrastructure faced severe constraints, with demand for specialists outpacing supply by 95 percent. Often, patients had to wait in long lines just to see a doctor and pick up a prescription before catching a bus back to their village. One such trip could take an entire day and was too costly for patients, especially those who needed to make several trips to complete the treatment. Lack of income often forced millions of poor people in India to forgo medical care altogether.
In 2014, the Government of Jharkhand set out to change this. With IFC’s support, the state structured its first health public-private partnership (PPP) and set up a network of modern diagnostic centers to provide comprehensive radiology and pathology diagnostic services.
The project mobilized about $12 million in private sector investment and generated annual payments of about $400,000 for state government to help cover the costs of subsidizing low-income patients. With better technology, efficiency, skilled health staff, and speedy service, 3.5 million residents per year are expected to benefit from better primary and preventive health care, including basic and advanced diagnostics in oncology, cardiology, urology, and other pathology services at affordable prices.
The first step Jharkhand’s 24 districts took to give its poor people better health care options was to adopt the “hub and spoke” PPP model—in which services are distributed and routed into and out of a central location. Below-poverty-line patients receive free radiology and pathology services from smaller district and village hospitals (known as the spokes). The patients who need more thorough examination and treatment are referred to large district hospitals and three state-run medical colleges (known as the hubs). The model helps doctors in the most rural areas and small towns provide quick and accurate diagnoses, eliminating unnecessary travel and medication and keeping the costs low for medical facilities and patients.
Two leading pathology service providers, SRL Limited and Medall Healthcare, signed 10-year concession contracts to build, operate, and transfer the facilities back to the state government. A joint venture between Manipal and Philips signed a concession contract with the state government to set up radiology services across all the state districts. The government reimburses the contractor for the free services to keep the model viable for the private sector and ensure that it meets demand, generates economies of scale, and balances service quality and affordability.
This ultimately made a huge difference in Devi’s pregnancy: she was able to see a local doctor who referred her to a hub in Ranchi, Jharkhand’s capital. There she saw a specialist and received free prenatal care, including pathology tests and an ultrasound. It helped prevent potential health problems at the end of her pregnancy without breaking her already-stretched family budget.
Encouraged by the results of the new PPP model that IFC helped introduce—and by the knowledge and experience gained working with IFC to structure the transaction—the state government then used its in-house capacity to structure a separate dialysis PPP. Eight hospitals are currently working to provide space and basic facilities for a private operator to equip and operate dialysis units, with free services for the poor.
This will help ease the load for overstretched district hospitals, boosting the efficiency of smaller hospitals that provide local routine and specialized care to thousands of low-income patients. It will also reduce patients’ time and travel. Future services expected to benefit from the new model are maternal and child care, first-aid and emergency services, gynecology, pediatrics, general surgery, and basic pathology.
Demand for health care is growing rapidly in developing countries. IFC’s roles include direct and indirect investment in health-care and life-sciences companies, sharing industry knowledge, raising management and clinical standards, informing government policy, and supporting public-private collaboration in health. With this first-of-its-kind, market-changing PPP, IFC is helping Jharkhand to transform its health care system and ensure equitable access to high-quality services to those most in need.
To learn more about IFC’s work in public-private partnerships, visit www.ifc.org/ppp
Published in May 2017